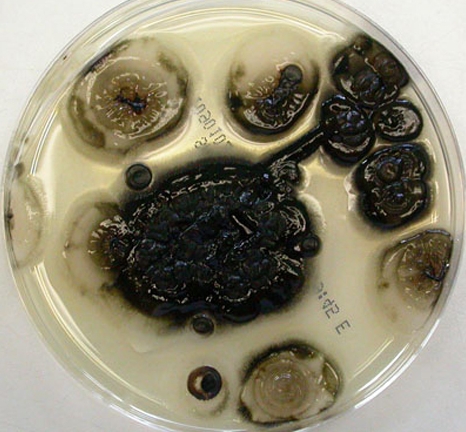
圖片關鍵詞 https://mmbiz.qpic.cn/mmbiz_png/EzTg6Bqtpm0WKZfQibicEjcQDNRWNq3jm7R1O13yKbpxibaicolLZIbOF5LU6gR9iazXNRiaLcwHXLXvzalbtAofl5YQ/640?wx_fmt=png

改善合并癥新冠患者免疫系統,科學家合作研究食用菌膳食補劑!
據《南美僑報網》報道,目前,巴拿馬、日本和印度三國科學家正聯手對一種食用菌膳食補劑在加強新冠肺炎合并癥患者免疫系統方面的功效進行研究。
據了解,上述科研小組包括來自巴拿馬科研暨高科技服務學院(INDICASAT-AIP)的科學家,研究對象是能夠在人體中產生化合物β-葡聚糖,從而到達免疫調節功能的的黑酵母菌AFO-202,即暗金黃擔子菌(Aureobasidium pullulans)。
由INDICASAT AIP學院派出的項目參與人員、專門從事營養保健品研究的有機化學家喬安特拉蓋伊(Johant Lakey)博士介紹,研究這種膳食補充劑的目的是通過減輕炎癥,加快新冠肺炎患者的康復過程,初步科研成果預計在9月或10月得出。
她解釋,高血壓、糖尿病、心血管疾病合并癥患者,本身免疫系統就相對脆弱,感染新冠病毒會加劇這一情況,從而引發過多炎癥,病死幾率隨之提高。
利用黑酵母AFO-202降低新冠肺炎死亡率的想法由日本山梨大學(University of Yamanashi)的印度裔心臟外科專家塞繆爾·亞伯拉罕(Samuel Abraham)博士提出,相關科研內容已于7月9日發表于知名學術雜志《免疫學前沿》。

亞伯拉罕介紹,日本生產含有黑酵母菌AFO-202的膳食補充劑已經長達24年,該產品早在1996年就已獲得日本厚生勞動省的官方認可。該有機化學成分對于癌癥患者、醫學研究志愿者和老年人免疫力的促進作用已經得到證實。
INDICASAT AIP學院院長札格納特拉奧(Jagannatha Rao,印度裔)指出:“ 新冠肺炎是一種極其復雜的疾病,在治療方法上,全球科學家已經做出了諸多嘗試。可以肯定的是,無論是哪種療法,都要以良好的人體免疫系統為基礎,這就是為什么巴拿馬的科學家團隊要對由日本生產的這種膳食補充劑進行研究。”
“除了作為治療和預后的工具之外,研究人員還在考慮將其用于預防感染。”札格納特拉奧補充道。
黑酵母菌AFO-202于上世紀80年代在日本首次被發現,直至現在,科學界一直認為該特定菌株的生長地點僅限于亞洲地區。然而,遠在中美洲地區的巴拿馬也已經意識到了食用真菌對于人體免疫力的促進作用。在巴拿馬衛生當局建議民眾食用的一系列能夠降低新冠病毒感染幾率的食品中,就包括蘑菇。(來源:南美僑報)
